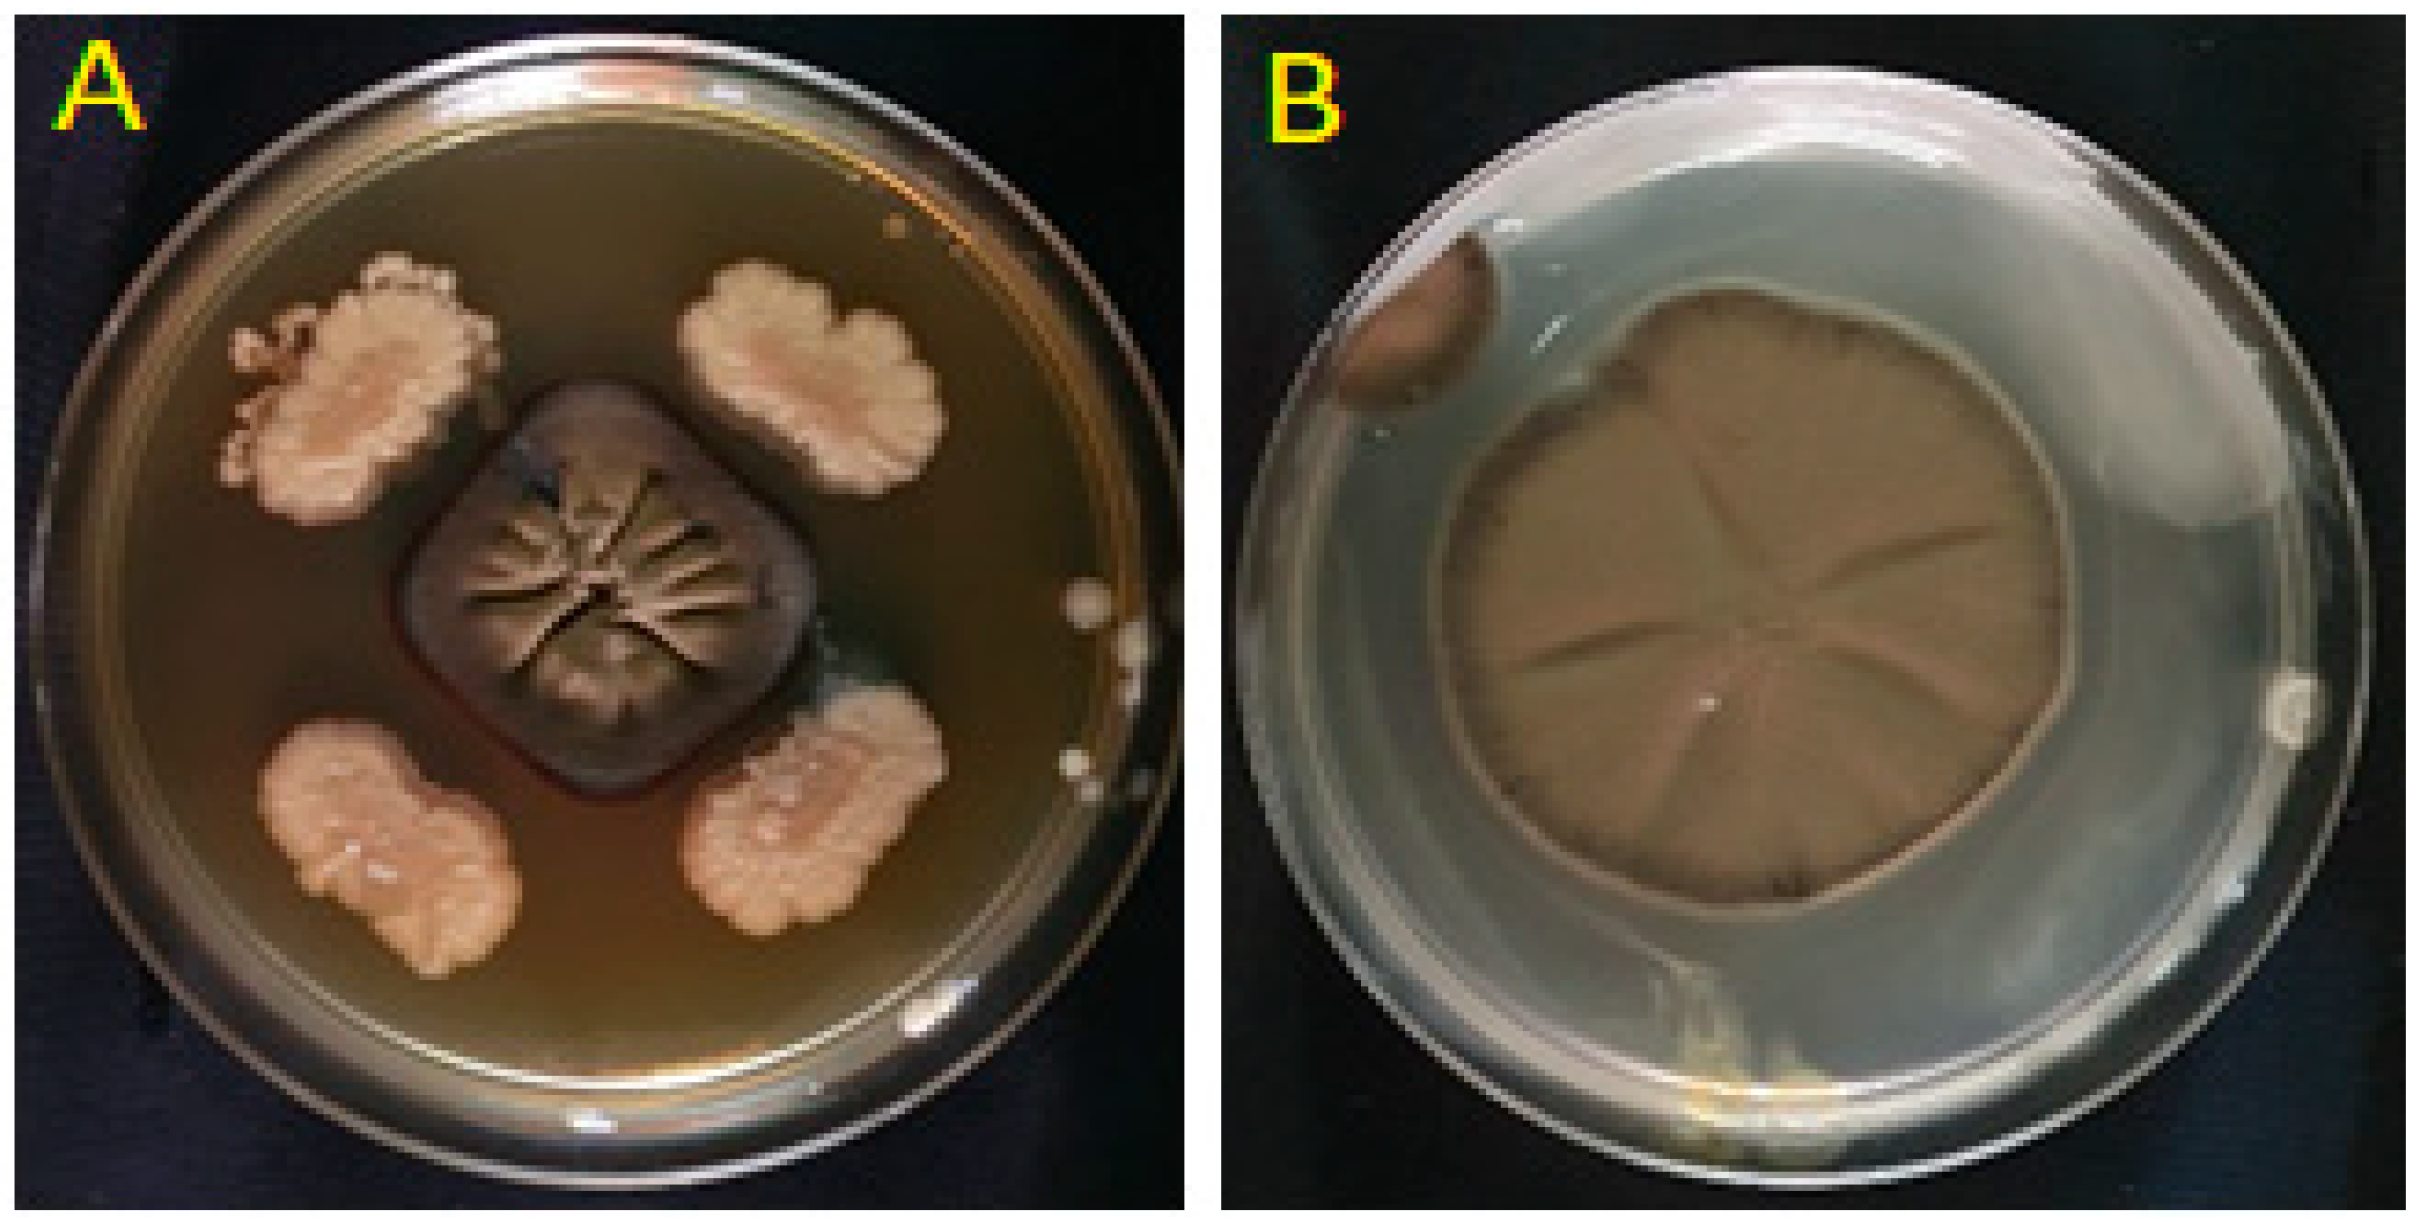

Biocontrol Potential of Rhizobacteria Against Passalora fulva and Tuta absoluta: A Sustainable Approach for Tomato Protection
Abstract
1. Introduction
2. Results
2.1. Isolation of Rhizobacteria from Tomato Rhizosphere
2.2. In Vitro Antagonism of P. fulva by Bacterial Isolates
2.3. Molecular Identification and Phylogenetic Characterization
2.4. Volatile Organic Compound (VOC) Activity Against P. fulva
2.5. Hydrogen Cyanide Production
2.6. Promotion of Tomato Growth Under Greenhouse Conditions
2.7. Biocontrol Activity Against P. fulva Under Greenhouse Conditions
2.8. Effects of Bacterial Isolates on Tuta absoluta Infestation
2.9. Principal Component Analysis (PCA)
3. Discussion
4. Materials and Methods
4.1. Isolation of Rhizosphere Bacteria
4.2. Antagonistic Effects
4.3. Molecular Identification of Bacterial Isolates
4.4. Volatile Organic Compound (VOC) Assay
4.5. Hydrogen Cyanide Production
4.6. Greenhouse Evaluation of Antagonistic Activity Against P. fulva
4.7. Evaluation of the Effects of Isolates on Tuta absoluta Under Greenhouse Conditions
4.8. Data Analysis
5. Conclusions
Author Contributions
Funding
Data Availability Statement
Acknowledgments
Conflicts of Interest
References
- Van Eck, J.; Kirk, D.D.; Walmsley, A.M. Tomato (Lycopersicum Esculentum). In Methods in Molecular Biology; Humana Press: Totowa, NJ, USA, 2006; Volume 343, pp. 459–473. ISBN 10.1385/1597451. [Google Scholar]
- Ait Hou, M.; Grazia, C.; Malorgio, G. Food Safety Standards and International Supply Chain Organization: A Case Study of the Moroccan Fruit and Vegetable Exports. Food Control 2015, 55, 190–199. [Google Scholar] [CrossRef]
- Bernal-Cabrera, A.; Martínez-Coca, B.; Herrera-Isla, L.; Ynfante-Martínez, D.; Peteira-Delgado, B.; Portal, O.; Leiva-Mora, M.; de Wit, P.J.G.M. The First Report on the Occurrence Race 9 of the Tomato Leaf Mold Pathogen Cladosporium fulvum (Syn. Passalora fulva) in Cuba. Eur. J. Plant Pathol. 2021, 160, 731–736. [Google Scholar] [CrossRef]
- Thomma, B.P.H.J.; Van Esse, H.P.; Crous, P.W.; De Wit, P.J.G.M. Cladosporium fulvum (Syn. Passalora fulva), a Highly Specialized Plant Pathogen as a Model for Functional Studies on Plant Pathogenic Mycosphaerellaceae. Mol. Plant Pathol. 2005, 6, 379–393. [Google Scholar] [CrossRef] [PubMed]
- Chouikhi, S.; Assadi, B.H.; Abbes, K.; Bkhiti, I.; Grissa Lebdi, K.; Belkadhi, M.S. Effectiveness of Mating Disruption with TUTATEC® Dispensers against Tuta absoluta (Lepidoptera: Gelechiidae) in Heated Greenhouses in Southern Tunisia. Phytoparasitica 2023, 51, 273–283. [Google Scholar] [CrossRef]
- Vivekanandhan, P.; Swathy, K.; Sarayut, P.; Patcharin, K. Biology, Classification, and Entomopathogen-Based Management and Their Mode of Action on Tuta absoluta (Meyrick) in Asia. Front. Microbiol. 2024, 15, 1429690. [Google Scholar] [CrossRef]
- Watanabe, H.; Horinouchi, H.; Muramoto, Y.; Ishii, H. Occurrence of Azoxystrobin-Resistant Isolates in Passalora Fulva, the Pathogen of Tomato Leaf Mould Disease. Plant Pathol. 2017, 66, 1472–1479. [Google Scholar] [CrossRef]
- Belabess, Z.; Gajjout, B.; Legrifi, I.; Barka, E.A.; Lahlali, R. Exploring the Antifungal Activity of Moroccan Bacterial and Fungal Isolates and a Strobilurin Fungicide in the Control of Cladosporium fulvum, the Causal Agent of Tomato Leaf Mold Disease. Plants 2024, 13, 2213. [Google Scholar] [CrossRef]
- Veloukas, T.; Bardas, G.A.; Karaoglanidis, G.S.; Tzavella-Klonari, K. Management of Tomato Leaf Mould Caused by Cladosporium fulvum with Trifloxystrobin. Crop Prot. 2007, 26, 845–851. [Google Scholar] [CrossRef]
- Herrera-Téllez, V.I.; Cruz-Olmedo, A.K.; Plasencia, J.; Gavilanes-Ruíz, M.; Arce-Cervantes, O.; Hernández-León, S.; Saucedo-García, M. The Protective Effect of Trichoderma asperellum on Tomato Plants against Fusarium oxysporum and Botrytis cinerea Diseases Involves Inhibition of Reactive Oxygen Species Production. Int. J. Mol. Sci. 2019, 20, 2007. [Google Scholar] [CrossRef]
- Gupta, R.; Keppanan, R.; Leibman-Markus, M.; Matveev, S.; Rav-David, D.; Shulhani, R.; Elad, Y.; Ment, D.; Bar, M. Bacillus thuringiensis Promotes Systemic Immunity in Tomato, Controlling Pests and Pathogens and Promoting Yield. Food Secur. 2024, 16, 675–690. [Google Scholar] [CrossRef]
- Hegde, G.M.; Malligawad, L.H.; Sreenivasa, M.N.; Chetri, B.K. Role of Plant Growth Promoting Microbes in the Control of Fungal Foliar Diseases of Tomato under Protected Cultivation. Egypt. J. Biol. Pest Control 2022, 32, 105. [Google Scholar] [CrossRef]
- Zhang, J.; Wu, L.F. Impact of Tillage and Crop Residue Management on the Weed Community and Wheat Yield in a Wheat–Maize Double Cropping System. Agriculture 2021, 11, 265. [Google Scholar] [CrossRef]
- Oulad Ziane, S.; Imehli, Z.; El Alaoui Talibi, Z.; Ibnsouda Koraichi, S.; Meddich, A.; El Modafar, C. Biocontrol of Tomato Verticillium Wilt Disease by Plant Growth-Promoting Bacteria Encapsulated in Alginate Extracted from Brown Seaweed. Int. J. Biol. Macromol. 2024, 276, 133800. [Google Scholar] [CrossRef]
- Qessaoui, R.; Lahmyed, H.; Ajerrar, A.; Furze, J.N.; Timothy, P.; Alouani, M.; Chebli, B.; Mayad, E.; Bouharroud, R. Rhizospheric Solutions: Pseudomonas Isolates Counter Botrytis cinerea on Tomato. Afr. Mediterr. Agric. J.-Al Awamia 2021, 131, 50–72. [Google Scholar] [CrossRef]
- El hjouji, H.; Qessaoui, R.; Chafiki, S.; Mayad, E.H.; Houmairi, H.; Dari, K.; Bencharki, B.; Aassila, H. Enhancement of Tomato Growth Through Rhizobacteria and Biocontrol of Associated Diseases. Life 2025, 15, 997. [Google Scholar] [CrossRef]
- Lahmyed, H.; Bouharroud, R.; Qessaoui, R.; Ajerrar, A.; Amarraque, A.; Aboulhassan, M.A.; Chebli, B. Actinomycete as Biocontrol Agents against Tomato Gray Mold Disease Caused by Botrytis cinerea. Kuwait J. Sci. 2021, 48, 1–8. [Google Scholar] [CrossRef]
- Elhjouji, H.; Qessaoui, R.; Houmairi, H.; Dari, K.; Bencharki, B.; Mayad, E.H.; Aassila, H. Biocontrol Potential of Bacillus Velezensis RS65 Against Phytophthora Infestans: A Sustainable Strategy for Managing Tomato Late Blight. Microorganisms 2025, 13, 656. [Google Scholar] [CrossRef] [PubMed]
- Conrath, U.; Pieterse, C.M.J.; Mauch-Mani, B. Priming in Plant-Pathogen Interactions. Trends Plant Sci. 2002, 7, 210–216. [Google Scholar] [CrossRef]
- Verhagen, B.W.M.; Trotel-Aziz, P.; Couderchet, M.; Höfte, M.; Aziz, A. Pseudomonas Spp.-Induced Systemic Resistance to Botrytis cinerea Is Associated with Induction and Priming of Defence Responses in Grapevine. J. Exp. Bot. 2010, 61, 249–260. [Google Scholar] [CrossRef]
- Qessaoui, R.; Bouharroud, R.; Furze, J.N.; El Aalaoui, M.; Akroud, H.; Amarraque, A.; Van Vaerenbergh, J.; Tahzima, R.; Mayad, E.H.; Chebli, B. Applications of New Rhizobacteria Pseudomonas Isolates in Agroecology via Fundamental Processes Complementing Plant Growth. Sci. Rep. 2019, 9, 12832. [Google Scholar] [CrossRef]
- Qessaoui, R.; Chafiki, S.; Mahroug, A.; Chabbi, N.; El Assri, S.; Ajerrar, A.; Hallam, J.; Tahiri, A.; Naima, A.A.; Alouani, M.; et al. Harnessing the Power of Pseudomonas for Sustainable Agriculture: Biofertilization and Biocontrol. Afr. Mediterr. Agric. J.-Al Awamia 2025, 146, 67–89. [Google Scholar] [CrossRef]
- Afzal, I.; Shinwari, Z.K.; Sikandar, S.; Shahzad, S. Plant Beneficial Endophytic Bacteria: Mechanisms, Diversity, Host Range and Genetic Determinants. Microbiol. Res. 2019, 221, 36–49. [Google Scholar] [CrossRef]
- Oukala, N.; Pastor, V.; Aissat, K. Bacterial Endophytes: The Hidden Actor in Plant Immune Responses against Biotic Stress. Plants 2021, 10, 1012. [Google Scholar] [CrossRef]
- Timofeeva, A.M.; Galyamova, M.R.; Sedykh, S.E. Plant Growth-Promoting Soil Bacteria: Nitrogen Fixation, Phosphate Solubilization, Siderophore Production, and Other Biological Activities. Plants 2023, 12, 4074. [Google Scholar] [CrossRef] [PubMed]
- Jeon, J.; Lee, S.; Kim, H.; Ahn, T. Plant Growth Promotion in Soil by Some Inoculated Microorganisms. J. Microbiol. 2003, 41, 271–276. [Google Scholar]
- Sultana, S.; Alam, S.; Karim, M.M. Screening of Siderophore-Producing Salt-Tolerant Rhizobacteria Suitable for Supporting Plant Growth in Saline Soils with Iron Limitation. J. Agric. Food Res. 2021, 4, 100150. [Google Scholar] [CrossRef]
- Uzma, M.; Nisar, A.; Iqbal, A.; Hasnain, S.; Mahmoud, M.H.; Rahim, M.A.; Gull, T.; Castro-Muñoz, R.; Zongo, E. Exploring the Efficacy of Drought Tolerant, IAA-Producing Plant Growth-Promoting Rhizobacteria for Sustainable Agriculture. Plant Signal. Behav. 2025, 20, 2452331. [Google Scholar] [CrossRef] [PubMed]
- Kashyap, A.S.; Manzar, N.; Rajawat, M.V.S.; Kesharwani, A.K.; Singh, R.P.; Dubey, S.C.; Pattanayak, D.; Dhar, S.; Lal, S.K.; Singh, D. Screening and Biocontrol Potential of Rhizobacteria Native to Gangetic Plains and Hilly Regions to Induce Systemic Resistance and Promote Plant Growth in Chilli against Bacterial Wilt Disease. Plants 2021, 10, 2125. [Google Scholar] [CrossRef] [PubMed]
- Gutiérrez-Mañero, F.J.; Ramos-Solano, B.; Probanza, A.; Mehouachi, J.; Tadeo, F.R.; Talon, M. The Plant-Growth-Promoting Rhizobacteria Bacillus pumilus and Bacillus licheniformis Produce High Amounts of Physiologically Active Gibberellins. Physiol. Plant 2001, 111, 206–211. [Google Scholar] [CrossRef]
- García de Salamone, I.E.; Hynes, R.K.; Nelson, L.M. Cytokinin Production by Plant Growth Promoting Rhizobacteria and Selected Mutants. Can. J. Microbiol. 2001, 47, 404–411. [Google Scholar] [CrossRef]
- Mishra, R.; Prakash, O.; Alam, M.; Dikshit, A. Influence of Plant Growth Promoting Rhizobacteria (PGPR) on the Productivity of Pelargonium graveolens L. Herit. Recent Res. Sci. Technol. 2010, 2, 53–57. [Google Scholar]
- Bates, K.A.; King, K.C. Leucobacter. Trends Microbiol. 2021, 29, 1046–1047. [Google Scholar] [CrossRef]
- Li, H.; Guo, Z.; Xu, M.; Zhao, J.; Xu, D. Molecular Mechanism of MiRNA Mediated Biosynthesis of Secondary Metabolites in Medicinal Plants. Plant Physiol. Biochem. 2024, 208, 108524. [Google Scholar] [CrossRef]
- Yadav, A.; Yadav, N.; Sachan, S.; Saxena, A.K. Biodiversity of Psychrotrophic Microbes and Their Biotechnological Applications. J. Appl. Biol. Biotechnol. 2019, 7, 99–108. [Google Scholar] [CrossRef]
- Styczynski, M.; Biegniewski, G.; Decewicz, P.; Rewerski, B.; Debiec-Andrzejewska, K.; Dziewit, L. Application of Psychrotolerant antarctic Bacteria and Their Metabolites as Efficient Plant Growth Promoting Agents. Front. Bioeng. Biotechnol. 2022, 10, 772891. [Google Scholar] [CrossRef] [PubMed]
- Bekkar, A.A.; Zaim, S. Newly Isolated Brevundimonas naejangsanensis as a Biocontrol Agent against Fusarium redolens the Causal of Fusarium Yellows of Chickpea. Folia Microbiol. 2024, 69, 835–846. [Google Scholar] [CrossRef] [PubMed]
- Kim, B.S.; Cho, K.Y. Antifungal Effects on Plant Pathogenic Fungi and Characteristics of Antifungal Substances Produced by Bacillus subtilis SJ-2 Isolated from Sclerotia of Rhizoctonia solani. Korean J. Plant Pathol. 1995, 11, 165–172. [Google Scholar]
- Wang, H.; Shi, Y.; Wang, D.; Yao, Z.; Wang, Y.; Liu, J.; Zhang, S.; Wang, A. A Biocontrol Strain of Bacillus Subtilis WXCDD105 Used to Control Tomato Botrytis cinerea and Cladosporium fulvum Cooke and Promote the Growth of Seedlings. Int. J. Mol. Sci. 2018, 19, 1371. [Google Scholar] [CrossRef]
- Myo, E.M.; Liu, B.; Ma, J.; Shi, L.; Jiang, M.; Zhang, K.; Ge, B. Evaluation of Bacillus velezensis NKG-2 for Bio-Control Activities against Fungal Diseases and Potential Plant Growth Promotion. Biol. Control 2019, 134, 23–31. [Google Scholar] [CrossRef]
- Kumar, S. Biopesticides: A Need for Food and Environmental Safety. J. Biofertil. Biopestic. 2012, 3, 4. [Google Scholar] [CrossRef]
- Martinez-Guerra, E.; Gude, V.G. Synergistic Effect of Simultaneous Microwave and Ultrasound Irradiations on Transesterification of Waste Vegetable Oil. Fuel 2014, 137, 100–108. [Google Scholar] [CrossRef]
- Ni, Z.J.; Wang, X.; Shen, Y.; Thakur, K.; Han, J.; Zhang, J.G.; Hu, F.; Wei, Z.J. Recent Updates on the Chemistry, Bioactivities, Mode of Action, and Industrial Applications of Plant Essential Oils. Trends Food Sci. Technol. 2021, 110, 78–89. [Google Scholar] [CrossRef]
- Jamali, H.; Sharma, A.; Roohi; Srivastava, A.K. Biocontrol Potential of Bacillus subtilis RH5 against Sheath Blight of Rice Caused by Rhizoctonia solani. J. Basic Microbiol. 2020, 60, 268–280. [Google Scholar] [CrossRef]
- He, C.N.; Ye, W.Q.; Zhu, Y.Y.; Zhou, W.W. Antifungal Activity of Volatile Organic Compounds Produced by Bacillus methylotrophicus and Bacillus thuringiensis against Five Common Spoilage Fungi on Loquats. Molecules 2020, 25, 3360. [Google Scholar] [CrossRef] [PubMed]
- Behiry, S.; Soliman, S.A.; Massoud, M.A.; Abdelbary, M.; Kordy, A.M.; Abdelkhalek, A.; Heflish, A. Trichoderma pubescens Elicit Induced Systemic Resistance in Tomato Challenged by Rhizoctonia solani. J. Fungi 2023, 9, 167. [Google Scholar] [CrossRef] [PubMed]
- Abdullah, R.R.H. The Efficacy of Chitinolytic Bacteria as a Bioinsecticide against Tuta absoluta (Lepidoptera: Gelechiidae). Int. J. Entomol. Res. 2020, 5, 107–110. [Google Scholar]
- Ben Khedher, S.; Boukedi, H.; Kilani-Feki, O.; Chaib, I.; Laarif, A.; Abdelkefi-Mesrati, L.; Tounsi, S. Bacillus amyloliquefaciens AG1 Biosurfactant: Putative Receptor Diversity and Histopathological Effects on Tuta absoluta Midgut. J. Invertebr. Pathol. 2015, 132, 42–47. [Google Scholar] [CrossRef] [PubMed]
- Schnepf, E.; Crickmore, N.; Van Rie, J.; Lereclus, D.; Baum, J.; Feitelson, J.; Zeigler, D.R.; Dean, D.H. Bacillus thuringiensis and Its Pesticidal Crystal Proteins. Microbiol. Mol. Biol. Rev. 1998, 62, 775–806. [Google Scholar] [CrossRef]
- Roxana, C. Microbial Inoculants Used to Control Tuta absoluta (Meyrick, 1917) (Lepidoptera: Gelechiidae). J. Hortic. For. Biotechnol. 2018, 22, 8–17. [Google Scholar]
- Ben Khedher, S.; Boukedi, H.; Laarif, A.; Tounsi, S. Biosurfactant Produced by Bacillus subtilis V26: A Potential Biological Control Approach for Sustainable Agriculture Development. Org. Agric. 2020, 10, 117–124. [Google Scholar] [CrossRef]
- Gholami, A.; Shahsavani, S.; Nezarat, S. The Effect of Plant Growth Promoting Rhizobacteria (PGPR) on Germination, Seedling Growth and Yield of Maize. Int. J. Biol. Sci. 2009, 1, 35–40. [Google Scholar]
- Dommergues, Y.; Mangenot, F. Ecologie Microbienne Du Sol; Masson: Paris, France, 1970; Volume 796. [Google Scholar]
- Atsamnia, D.; Hanini, S.; Oukrif, D.; Benachour, K.; Benkortbi, O.; Hamadache, M. Comparative Therapeutic Properties of Garlic Extract and Metformin on Hyperglycaemia, Hypercholesterolaemia, and Hypertriglyceridaemia in Alloxan-Induced Type1-like Diabetic Rats. J. Chem. Chem. Eng. Croat. 2022, 71, 141–149. [Google Scholar] [CrossRef]
- Patel, J.J.; Brown, M.E. Interactions of Azotobacter with Rhizosphere and Root-Surface Microflora. Plant Soil 1969, 31, 273–281. [Google Scholar] [CrossRef]
- Whipps, J.M. Effect of media on growth and interactions between a range of soil-borne glasshouse pathogens and antagonistic fungi. New Phytol. 1987, 107, 127–142. [Google Scholar] [CrossRef]
- Edwards, U.; Rogall, T.; Blöcker, H.; Emde, M.; Böttger, E.C. Isolation and Direct Complete Nucleotide Determination of Entire Genes. Characterization of a Gene Coding for 16S Ribosomal RNA. Nucleic Acids Res. 1989, 17, 7843–7853. [Google Scholar] [CrossRef]
- Fiddaman, P.J.; Rossall, S. The Production of Antifungal Volatiles by Bacillus subtilis. J. Appl. Bacteriol. 1993, 74, 119–126. [Google Scholar] [CrossRef] [PubMed]
- Kumari, S.; Khanna, V. Effect of Antagonistic Rhizobacteria coinoculated with Mesorhizobium ciceris on Control of Fusarium wilt in Chickpea (Cicer Arietinum L.). Afr. J. Microbiol. Res. 2014, 8, 1255–1265. [Google Scholar] [CrossRef]
- Bakker, A.W.; Schippers, B. Microbial Cyanide Production in the Rhizosphere in Relation to Potato Yield Reduction and Pseudomonas SPP-Mediated Plant Growth-Stimulation. Soil Biol. Biochem. 1987, 19, 451–457. [Google Scholar] [CrossRef]
- Jha, B.K.; Gandhi Pragash, M.; Cletus, J.; Raman, G.; Sakthivel, N. Simultaneous Phosphate Solubilization Potential and Antifungal Activity of New Fluorescent Pseudomonad Strains, Pseudomonas aeruginosa, P. plecoglossicida and P. mosselii. World J. Microbiol. Biotechnol. 2009, 25, 573–581. [Google Scholar] [CrossRef]
- Kang, B.R.; Ko, S.-J.; Kim, D.-I.; Choi, D.-S.; Kim, S.-G. Determination of Proper Application Timing and Frequency for Management of Tomato Leaf Mold Disease by Commercially Available Microbial Preparations. Res. Plant Dis. 2011, 17, 142–147. [Google Scholar] [CrossRef]
- Batchimeg, T.; Dondov, B. Results of Bacillus subtilis against Major Diseases on Greenhouse Crops. Mong. J. Agric. Sci. 2015, 15, 134–137. [Google Scholar] [CrossRef]

| Strain Code | Genus | Accession | Similarity (%) | E-Value | Coverage (%) |
|---|---|---|---|---|---|
| IQR1 | Leucobacter | ON799334.1 | 99.18 | 0.0 | 100 |
| IQR2 | Paenochrobactrum | JF804769.1 | 96.25 | 5 × 10−170 | 95 |
| IQR3 | Psychrobacter | JQ337400.1 | 100 | 0.0 | 100 |
| IQR5 | Brevundimonas | KF816539.1 | 100 | 8 × 10−126 | 100 |
Disclaimer/Publisher’s Note: The statements, opinions and data contained in all publications are solely those of the individual author(s) and contributor(s) and not of MDPI and/or the editor(s). MDPI and/or the editor(s) disclaim responsibility for any injury to people or property resulting from any ideas, methods, instructions or products referred to in the content. |
© 2025 by the authors. Licensee MDPI, Basel, Switzerland. This article is an open access article distributed under the terms and conditions of the Creative Commons Attribution (CC BY) license (https://creativecommons.org/licenses/by/4.0/).
Share and Cite
Bahoch, S.; Elaasri, A.; Chafiki, S.; Elame, F.; Wifaya, A.; Mayad, E.h.; Bouharroud, R.; Qessaoui, R. Biocontrol Potential of Rhizobacteria Against Passalora fulva and Tuta absoluta: A Sustainable Approach for Tomato Protection. Plants 2025, 14, 2672. https://doi.org/10.3390/plants14172672
Bahoch S, Elaasri A, Chafiki S, Elame F, Wifaya A, Mayad Eh, Bouharroud R, Qessaoui R. Biocontrol Potential of Rhizobacteria Against Passalora fulva and Tuta absoluta: A Sustainable Approach for Tomato Protection. Plants. 2025; 14(17):2672. https://doi.org/10.3390/plants14172672
Chicago/Turabian StyleBahoch, Said, Abdessamad Elaasri, Salahddine Chafiki, Fouad Elame, Ahmed Wifaya, El hassan Mayad, Rachid Bouharroud, and Redouan Qessaoui. 2025. "Biocontrol Potential of Rhizobacteria Against Passalora fulva and Tuta absoluta: A Sustainable Approach for Tomato Protection" Plants 14, no. 17: 2672. https://doi.org/10.3390/plants14172672
APA StyleBahoch, S., Elaasri, A., Chafiki, S., Elame, F., Wifaya, A., Mayad, E. h., Bouharroud, R., & Qessaoui, R. (2025). Biocontrol Potential of Rhizobacteria Against Passalora fulva and Tuta absoluta: A Sustainable Approach for Tomato Protection. Plants, 14(17), 2672. https://doi.org/10.3390/plants14172672

